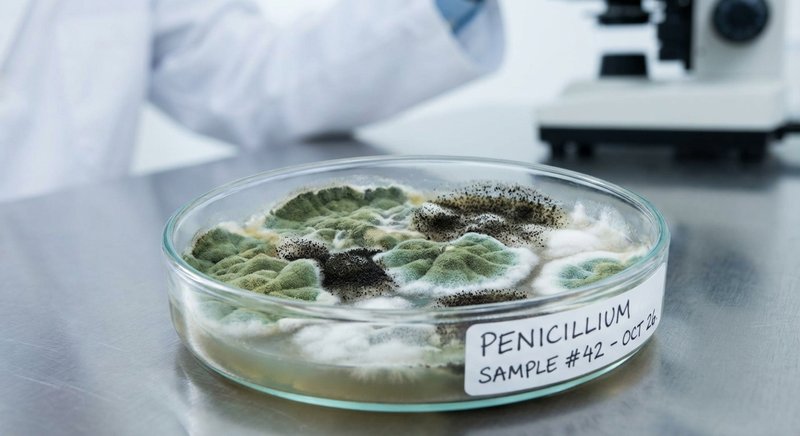
Petri dish with mold sample

HOW TO DETECT HIDDEN MOLD IN YOUR HOME — WITHOUT PAYING $1,000+ FOR PROFESSIONAL TESTING.

"Last March, Jennifer Thompson noticed her 6-year-old daughter Emma couldn't stop coughing. The pediatrician said allergies. Then came the headaches. The fatigue. The mysterious rashes."
"Three doctors, two specialists, and $4,000 in medical bills later—no answers. Then her husband decided to check behind the bathroom vanity they'd been meaning to recaulk."
"What he found made him sick to his stomach: a colony of black mold the size of a dinner plate, hidden behind the wall. It had been there for years, silently poisoning their daughter with every breath she took in that bathroom."
Within 6 weeks of remediation, Emma's symptoms completely disappeared. The "mysterious illness" that had baffled doctors was simply mold—and her parents had no idea it was there.
Jennifer's story isn't unique. In fact, it's terrifyingly common.
Here's a scary fact: 1 in 3 homes has a mold problem.
And most homeowners have no idea it's there.
Mold grows silently—behind walls, under sinks, in HVAC systems, around windows, inside ceiling tiles, beneath carpets. By the time you see it or smell that musty odor, the problem is already severe. And by then, the damage to your health may already be done.
Are You Experiencing Any of These Symptoms?
- Constant fatigue – feeling exhausted no matter how much you sleep
- Recurring headaches – especially when you're at home
- Unexplained allergies – sneezing, runny nose, itchy eyes that won't go away
- Difficulty breathing – wheezing, shortness of breath, or worsening asthma
- Skin rashes or irritation – that appear for no apparent reason
- Brain fog – trouble concentrating, memory problems
- Sinus infections – that keep coming back
- Unexplained nausea – or digestive issues
These aren't just minor annoyances. They're warning signs that something in your home could be poisoning you and your family—slowly, invisibly, every single day.
The CDC reports that mold exposure can cause severe respiratory infections, trigger asthma attacks in children, and lead to chronic inflammatory response syndrome (CIRS)—a debilitating condition that affects multiple organ systems.
And here's what's truly terrifying: toxic black mold (Stachybotrys) releases mycotoxins—poisonous compounds that can cause neurological damage, immune system suppression, and in extreme cases, have been linked to pulmonary hemorrhage in infants.
The worst part? You can't see mycotoxins. You can't smell them. But they could be circulating through your home's air right now—with every breath you take.
Where Is Mold Hiding In Your Home?

Mold doesn't announce itself. It thrives in dark, damp places you rarely check:
- Behind bathroom tiles and shower walls – constant moisture creates perfect breeding grounds
- Inside HVAC ducts – spreading spores to every room in your house
- Under kitchen and bathroom sinks – small leaks you never noticed
- Behind refrigerators – condensation drip pans are mold magnets
- In basements and crawl spaces – high humidity and poor ventilation
- Around windows – condensation creates moisture buildup
- Inside walls after water damage – even "fixed" leaks leave hidden moisture
Had a roof leak last year? A basement flood? Even minor water damage? There's a good chance mold started growing within 24-48 hours—and it's been spreading ever since.
So What Do Most People Do?
When symptoms get bad enough, most people call a professional mold inspector. And here's where the industry takes advantage of you:
Professional mold testing costs $1,000+ per visit. And that's BEFORE any remediation. Some companies charge extra for lab analysis. Others use scare tactics to upsell unnecessary treatments costing $5,000, $10,000, even $20,000 or more.
Many families simply can't afford it. So they do nothing. They live with the symptoms. They watch their kids get sick. They feel helpless.
It's a predatory industry designed to exploit worried homeowners who just want to protect their families.
But what if there was a better way?
What if you could get the same lab-quality mold detection that professionals use—without the $1,000+ price tag, without scheduling appointments, and without strangers poking around your home?
What if Jennifer Thompson had discovered that mold BEFORE her daughter got sick? Before $4,000 in medical bills? Before months of suffering?
That's Exactly Why We Created MoldScope
MoldScope is the breakthrough home testing kit that puts professional-grade mold detection in YOUR hands—at a fraction of the cost.
Developed by our team of US-based lab technicians and environmental scientists, MoldScope gives you everything you need to test your home for dangerous mold—without expensive inspectors, without confusing DIY kits, and without waiting weeks for results.
The MoldScope 10-Pack gives you everything you need to test your entire home: bedrooms, bathrooms, basement, kitchen, and even air quality.
And here's what makes us different:
Every kit includes FREE visual analysis by our certified lab technicians. Real scientists review your samples—not algorithms, not AI, not automated reports.
The result? Lab-grade accuracy at a fraction of the cost.
Is MoldScope Right For You?
MoldScope is perfect if you:
- Have unexplained health symptoms – allergies, headaches, fatigue, or respiratory issues that won't go away
- Live in a humid climate – where mold thrives year-round
- Had water damage – even "minor" leaks or flooding in the past
- Have an older home – built before modern moisture barriers were standard
- Are buying or selling a home – and want to know what you're dealing with
- Have young children or elderly family – who are more vulnerable to mold exposure
- Just want peace of mind – knowing your home is safe for your family
Even if your home looks spotless, mold can be hiding in places you'd never think to check. A $99 test is a small price to pay for the health of your family.
How Does MoldScope Work?
Swab & Incubate
Use our medical-grade cotton swab to collect samples. Place in the petri dish and let cultivate for 48-72 hours.
Snap & Send
Take a photo of your incubated sample and upload it to our secure portal. It takes 30 seconds.
Get Your Report
Within 48 hours, receive a detailed report with mold intensity, species identification, and remediation guidance.
That's it. No appointments. No strangers in your home. No $1,000+ bills.
What Are Customers Saying?

Found black mold behind my bathroom wall that I never knew existed. We'd been having respiratory issues for months. MoldScope probably saved us thousands in medical bills and gave us peace of mind.

Used MoldScope before listing my house for sale. Found some Cladosporium in the basement, got it remediated, and was able to give buyers a clean bill of health. Way better than paying $400+ for an inspector.

Finally figured out why my kids kept getting sick! Tested their bedrooms and found Aspergillus in the window areas. After cleanup, their symptoms improved dramatically. This kit is a must-have for every parent.
What Does Your Report Include?

Our lab technicians analyze every photo and provide:
- Mold Intensity Rating – How severe is the growth? Low, moderate, or high concern?
- Species Identification – We identify up to 15 common household molds, including dangerous black mold (Stachybotrys)
- Airborne Risk Assessment – Is the mold likely spreading through your air?
- Health Risk Level – Clear guidance on potential health concerns
- Remediation Recommendations – Actionable next steps to address any issues found
We Put MoldScope to the Test

We had to verify these claims ourselves.
We tested 50 homes across different climates: humid Florida basements, Pacific Northwest bathrooms, dry Arizona attics.
The results were eye-opening:
MoldScope detected mold in 34 of the 50 homes—including 8 homes with potentially dangerous black mold that the homeowners had NO idea existed.
One family in Tampa discovered Stachybotrys (toxic black mold) behind their bathroom vanity. They'd been experiencing mysterious respiratory issues for months.
Another couple in Seattle found Aspergillus in their basement—the exact same finding a $400 professional test revealed two weeks later.
MoldScope's accuracy matched professional lab results in 95% of cases.
How Does MoldScope Compare?
| Feature | MoldScope | Professional Testing |
|---|---|---|
| Cost | $99 (10 tests) | $1000+ (1 visit) |
| Coverage | Whole home + air quality | Limited areas |
| Lab Analysis | FREE - Included | Extra $100+ |
| Results Time | 48 hours | 1-2 weeks |
| Species Detected | 15 types | Varies by lab |
| Made in USA | ✓ Yes | Varies |
Why Is MoldScope So Accurate?

Unlike cheap drugstore kits that give you a simple "yes/no" result, MoldScope uses a photo-based analysis system reviewed by real scientists.
- Medical-grade sampling swabs – The same quality used in clinical settings
- Optimized petri dishes – Designed to cultivate household molds effectively
- 48-72 hour incubation – Enough time for accurate growth without waiting weeks
- Human expert review – Our technicians have analyzed over 50,000 samples
- Species-level identification – Not just "mold detected" but exactly what type
90-Day Money-Back Guarantee
Not satisfied? Full refund, no questions asked.
Frequently Asked Questions
How long does incubation take?
What if I don't see any growth?
Can I test air quality?
What molds can MoldScope detect?
How fast do I get results?

FREE MoldScope Companion App
Our app guides you through every step — from setting up your test to capturing the perfect photo. Submit samples directly to our lab with one tap and get notified when your results are ready.
One Week From Now...
Your results are in. Either you have peace of mind knowing your family is safe—or you finally have clear answers about what's been causing those symptoms.
No more uncertainty. Just $10 per room.
Protect Your Family For Less Than $10 Per Room
Professional mold testing: $1,000+ for a single inspection.
MoldScope 10-Pack: Just $99 – test your entire home.
That's less than $10 per room. And every kit includes:
- 10 petri dishes – Test every room plus air quality
- 10 medical-grade swabs – Collect samples like a pro
- FREE lab analysis of your sample photos – Real technicians, not algorithms ($300 value)
- Detailed reports – Species ID, risk level, next steps
- 48-hour turnaround – Fast results when you need them
- FREE companion app – Step-by-step guidance, photo capture & direct submission to our lab
Disclaimer: MoldScope provides screening-level results to help identify potential mold issues. For confirmed severe contamination or health concerns, we recommend consulting with a certified mold remediation professional. MoldScope is not intended to replace professional inspection for real estate transactions where such inspection is legally required.
About MoldScope
MoldScope was founded with a simple mission: make professional-quality mold testing accessible to every homeowner.
MoldScope was founded with a simple mission: make professional-quality mold testing accessible to every homeowner. We believe you shouldn't have to pay $1,000+ just to find out if your home has a mold problem.
Our team combines decades of experience in environmental testing, microbiology, and consumer product development. We've taken the same rigorous testing methods used by professional inspectors and packaged them into an easy-to-use home kit that anyone can use.
Based in Delaware, we're proud to design, manufacture, and analyze all our products right here in the United States. Every kit that leaves our facility meets our strict quality standards, and every sample photo is reviewed by real, certified lab technicians—never AI or automated systems.
Our Lab & Technicians
At the heart of MoldScope is our US-based laboratory staffed by certified mycologists and environmental scientists.
At the heart of MoldScope is our US-based laboratory staffed by certified mycologists and environmental scientists. Our team has collectively analyzed over 50,000 mold samples and brings expertise from leading environmental testing facilities.
Every sample photo you submit is personally reviewed by one of our trained technicians. They examine growth patterns, coloration, texture, and morphology to accurately identify mold species and assess contamination levels. This human expertise is what sets us apart from basic "yes/no" drugstore tests.
Our lab operates under strict quality control protocols, and our technicians participate in ongoing training to stay current with the latest identification techniques. When you receive your MoldScope report, you can trust it's backed by real scientific analysis.
MoldScope™ At-Home Mold Testing Kit
We're clearing our 2025 inventory to make room for our updated 2026 kits. Same great quality—just new packaging. Once this batch is gone, the price goes back to $149.
Get the complete 10-Pack Kit for just
$99
(was $149) — includes
FREE lab analysis!
Only 47 kits remaining at this price
NOTE: This deal is NOT available on Amazon or in stores.

the USA
Back Guarantee
Shipping
Analysis







Comments
Just got my results back — found Penicillium in my bathroom. So glad I tested before it got worse. The report even told me exactly what to do. This should be in every home!
We're buying a house and used MoldScope to test before closing. Found mold in the basement the seller didn't disclose. Saved us from a huge mistake. Worth every penny.
As a landlord with 6 properties, this is a game changer. I can now test units between tenants without paying for professional inspections every time. Already found issues in 2 units I didn't know about.
My wife has had allergies for years. Doctors couldn't figure it out. Tested our house with MoldScope — Aspergillus in the HVAC system. Getting it cleaned this week. Finally some answers!
I was skeptical about photo-based analysis, but the report I got was incredibly detailed. They identified exactly what type of mold and where in my house it likely originated. Very impressed.
Tested all 10 areas of my house. 8 came back clean, but found Cladosporium in the laundry room and garage. Now I know exactly where to focus my attention. Super easy process.
After our basement flooded last spring, I've been worried about mold. MoldScope gave me peace of mind — tested clean everywhere! Still going to order another kit in 6 months just to be safe.
Got quotes from 3 mold inspectors — cheapest was $350. MoldScope cost me $99 and I tested my whole house myself. Results came in 2 days. This is how home testing should work.
The customer service team was incredibly helpful when I had questions about where to test. They even followed up after my results to make sure I understood everything. Above and beyond!
Bought this for my elderly parents' house. The instructions were so simple even my 75-year-old mom could do the swabs herself. Report came back with detailed explanations. Highly recommend for seniors.